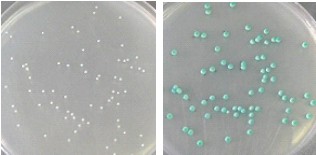
念珠菌显色对照培养基

念珠菌显色对照培养基
| 【编号】:135014-201001
【产品名称】:念珠菌显色对照培养基 【规格】:4.8g/100ml 【用途】:培养基适用性实验 ![]() 念珠菌显色对照培养基分析证书( COA)
中文名称:念珠菌显色对照培养基
英文名称:Candida Chromatic Agar Reference Medium(CCARM)
配方:配制每 L 培养基需干粉 47.7g,配方如下:
胨 10.2g 葡萄糖 20.0g 氯霉素 0.5g
琼脂 15.0g 色素 2.0g
外观:本品为淡黄色均一粉末,加入水中混悬均匀,灭菌后融化状态时为黄色透明液体。
装量:本品标示装量 4.8g/袋/100mL,平均装量 4.80g/袋,RSD=0.23%(n=10,S=0.01g)。
酸度:本品灭菌后 pH6.0。
生长能力&指示能力:取 2010 版中国药典收载的白色念珠菌 (Candida albicans)[CMCC(F) 98001],以 50-100cfu 接种至该批培养基中,30-35℃培养 24 小时后,测试菌株均生长良好,菌落形态如下图。
![]()
左图:白色念珠菌在该批念珠菌显色对照培养基表面培养 24 小时的生长形态;
右图:白色念珠菌在该批念珠菌显色对照培养基表面培养 48 小时的生长形态。
抑制能力:取 2010 版中国药典收载的大肠埃希菌 (Escherichia coli) [CMCC(B)44102],以 100-1000cfu 接种至该批培养基,30-35℃培养 72 小时后,测试菌株均未见生长。
该批对照培养基满足 2010 年版《中国药典》培养基适用性实验的要求,可用于培养基适用性检查对比实验。
|
| 上一篇:沙氏葡萄糖琼脂对照培养基 | 下一篇:绿脓菌素测定用对照培养基基础 |
|---|